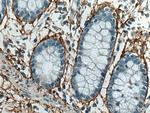
MFAP5 Antibody in Immunohistochemistry (Paraffin) (IHC (P))

Search
Proteintech
MFAP5 Polyclonal Antibody
{{$productOrderCtrl.translations['antibody.pdp.commerceCard.promotion.promotions']}}
{{$productOrderCtrl.translations['antibody.pdp.commerceCard.promotion.viewpromo']}}
{{$productOrderCtrl.translations['antibody.pdp.commerceCard.promotion.promocode']}}: {{promo.promoCode}} {{promo.promoTitle}} {{promo.promoDescription}}. {{$productOrderCtrl.translations['antibody.pdp.commerceCard.promotion.learnmore']}}
产品信息
15727-1-AP
种属反应
已发表种属
宿主/亚型
分类
类型
抗原
偶联物
形式
浓度
规格
纯化类型
保存液
内含物
保存条件
运输条件
产品详细信息
Immunogen sequence: NSQRGDDVT QATPETFTED PNLVNDPATD ETVLAVLADI APSTDDLASL SEKNTTAECW DEKFTCTRLY SVHRPVKQCI HQLCFTSLRR MYIVNKEICS RLVCKEHEAM KDELCRQMAG LPPRRLRRSN YFRLPPCENV DLQRPNGL (27-173 aa encoded by BC005901 )
靶标信息
This gene encodes a 25-kDa microfibril-associated glycoprotein which is rich in serine and threonine residues. It lacks a hydrophobic carboxyl terminus and proline-, glutamine-, and tyrosine-rich regions, which are characteristics of a related 31- kDa microfibril-associated glycoprotein (MFAP2). The close similarity between these two proteins is confined to a central region of 60 aa where precise alignment of 7 cysteine residues occurs. The structural differences suggest that this encoded protein has some functions that are distinct from those of MFAP2.
仅用于科研。不用于诊断过程。未经明确授权不得转售。
生物信息学
蛋白别名: MAGP-2; MFAP-5; Microfibril-associated glycoprotein 2; microfibril-associated glycoprotein-2; microfibrillar associated protein 5; Microfibrillar-associated protein 5; MP25; THE1A-MFAP5; unnamed protein product
基因别名: AAT9; MAGP-2; MAGP2; MFAP-5; MFAP5; MP25
UniProt ID: (Human) Q13361
Entrez Gene ID: (Human) 8076